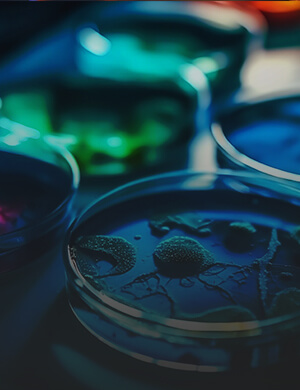

Návšteva členov Medzinárodného poradného výboru
V utorok 9. decembra 2025 navštívili Centrum biovied SAV členovia Medzinárodného poradného výboru CBv. Cieľom stretnutia bolo predstaviť Centrum biovied SAV, jeho výskumné skupiny a diskutovať o aktuálnych výskumných...
Navštív svoju školu – Spoznaj svojho vedca
Kolegovia z Oddelenia biofyziky a elektrofyziológie ÚMFG CBv SAV sa tento rok zapojili do iniciatívy agentúry SOVVA „Navštív svoju školu –...
Mikuláš opäť navštívil Centrum biovied SAV
V sobotu 6. decembra 2025 zavítal Mikuláš na Centrum biovied SAV, kde sa v zasadačke Ústavu biochémie a genetiky živočíchov stretli...
Chytré biosenzory – workshop pre stredoškolákov
14.11.2025 sme v Centre biovied SAV privítali stredoškolákov z rôznych kútov Slovenska na popularizačnom podujatí venovanom moderným prístupom v diagnostike rakoviny. Workshop sa konal...
Mitochondriálny patch-clamp – nové možnosti elektrofyziologického výskumu na CBv SAV
Dve naše kolegyne z Oddelenia biofyziky a elektrofyziológie ÚMFG CBv SAV navštívili 05.11. – 07.11.2025 elektrofyziologické laboratórium prof. Piotra Bednarzyka na...